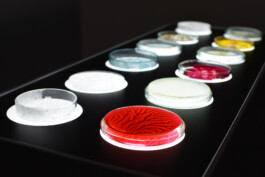
Miriam Hausner

Im Wandel der Stoffe
Neospektiv
Das Verhalten ephemerer Stoffe bietet in jedem Moment einen neuen ästhetischen Eindruck, der auf identische Weise nicht reproduzierbar ist. Ob Nebel, Wind, Wasser oder Feuer – ein komplexes System verschiedenster Parameter sorgt dafür, dass der Betrachter den nächsten Veränderungsmoment, die nächste Abzweigung nicht voraussehen kann und als zufällig deutet. Der Wandel unterschiedlichster Substanzen und die Analyse des festen und stabilen Regelwerks, das immer wieder flüchtige und instabile Zustände von Form, Farbe und Struktur hervorruft, wurden mit dem Ziel untersucht, die stetig der Neuordnung unterworfene Gestalt der Stoffe als Ausdrucksform auf multisensorischer Ebene zu nutzen. Das Seminar fand an der Hochschule Düsseldorf im Wintersemester 2018/2019 unter der Leitung von Thomas Wirtz statt. Die Ergebnisse wurden im Rahmen einer Ausstellung in Kooperation mit neospektiv Düsseldorf, sowie Frédéric Wiegand präsentiert.

Neospektiv
01.02.–02.02.2019
Konzeption und Kuration
Lara Bechauf-Ngyuen, Miriam Hausner, Anne-Cathrine Mosbach, Frédéric Wiegand & Thomas Wirtz / aerosoap
Seminarkonzept, Betreuung
Thomas Wirtz
In Kooperation mit
Peter Behrens School or Arts, Hochschule Düsseldorf
Mit Arbeiten von
Joseph Abramov, Luca Brescia, Michael Boucke, Dagmar Buchenthal, Darius Büsch, Jasmin Dathe, Ghenwa Dehaini, Cosima Dinort, Merit Dippel, Annika Drießen, Kris dos Santos Castanheira, Sinem Duran, Marie Viertel, Patricia Ekkert, Emilia Fischer, Maxine Friedrich, Cathrin Fürbach, Danial Ebrahimnejad Ghods, Jonathan Gnoth, Lorenz Grohmann, Mariama Jeng, Joel Kimbangu Mundonga, Kylie Krämer, David Krieger, Lucien Kullat, Britta Khaeef, Antonia Lübbars, Charlotte Meisl, Tim Minkenberg, Ksenia Nikolaeva, Rebecca Pajares Hammacher. Ellen Rohrbach, Emily Schoeme, Max Schropp, Victor Shohreh, Laurien Weber, Rebecca Wieler, Mara Wolf
Fotos
Max Brugger, Frédéric Wiegand
Tätigkeitsfelder
Kuration, Ausstellungskonzeption- und management, Produktion
Kontakt
mail@miriam-hausner.de
+49 176 98597164


























